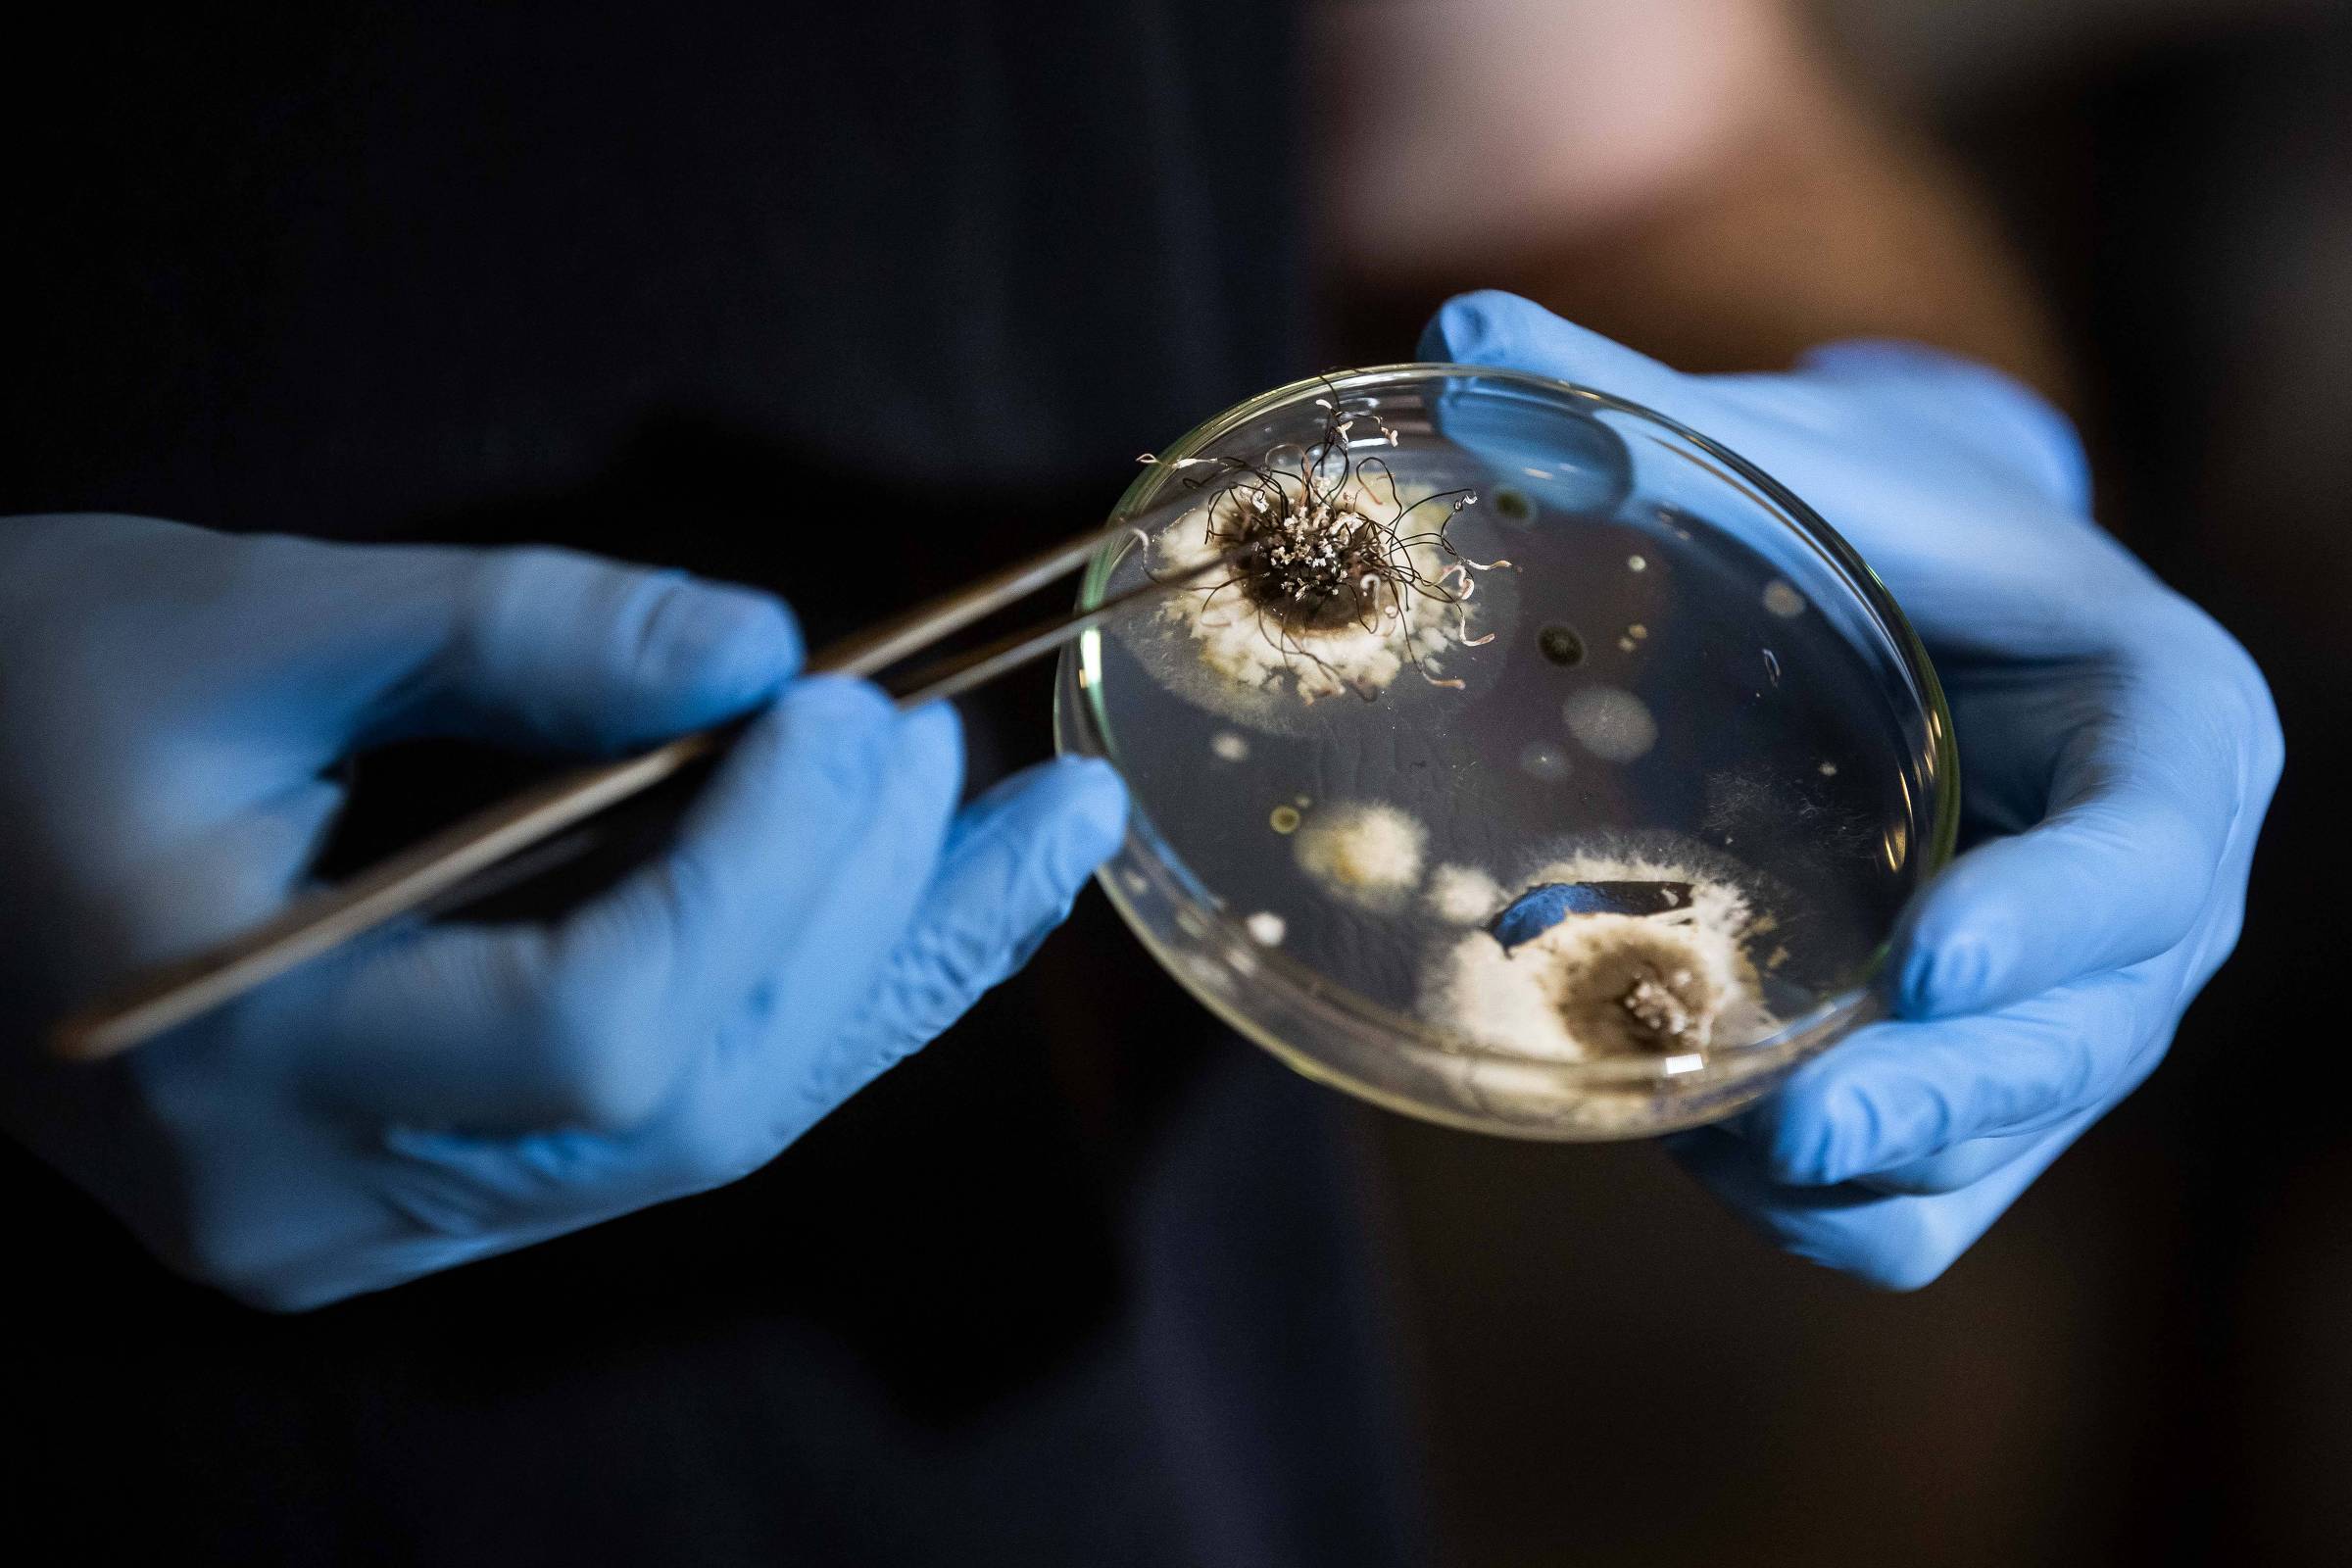

A) receives applications for scholarships from the José Reis Incentive Program until April 11th. The initiative seeks to encourage the training of professionals capable of producing and disseminating information about science and for different media.
The scholarships are intended for undergraduate students and professionals with degrees in any field, as long as they do not have an employment relationship and have completed or are currently taking an introduction course to scientific journalism with a minimum workload of 90 hours.
Among the selection criteria, Fapesp prioritizes proposals linked to scientific or technological research projects supported by the Foundation itself.
The scholarships vary according to the table below:
| Regular Scholarships | Values in force from 08/01/2025 |
| Scientific Initiation (IC) | R$ 1.140 |
| Mestrado I (MS-I) | R$ 3.270 |
| Master II (MS-II) | R$ 3.450 |
| Direct Doctorate I (DD-I) and Direct Doctorate II (DD-II) | R$ 5.790 |
| Direct Doctorate III (DD-III) and Direct Doctorate IV (DD-IV) | R$ 7.140 |
| Doctorate I (DR-I) | R$ 5.790 |
| Doctorate II (DR-II) | R$ 7.140 |
| Post-Doctorate (PD) | R$ 12.570 |
The expectation is that the content produced explains to the public the scientific, social and economic relevance of research and contributes to expanding society’s access to quality scientific information.
Projects must result in the production of scientific dissemination content for vehicles such as newspapers, magazines, radio, podcasts, television and digital platforms, in parallel with the fulfillment of a study program in the area.
Registration can be made using the form available.
LINK PRESENT: Did you like this text? Subscribers can access seven free accesses from any link per day. Just click the blue F below.
your subscription could be worth even more
Do you already know the advantages of being a Folha subscriber? In addition to having access to reports and columns, you have exclusive newsletters (). You can also download our free app at or to receive alerts for the day’s top news. Your subscription helps us provide independent, quality journalism. Thanks!
your subscription is worth a lot
More than 180 reports and analyzes published every day. A team with more than 200 columnists and bloggers. Professional journalism that monitors public authorities, conveys useful and inspiring news, counteracts the intolerance of social media and draws a clear line between truth and lies. How much does it cost to help produce this content?